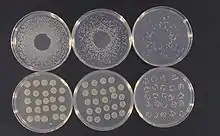

لکه زاویهای برگکدوئیان
لکه زاویهای برگکدوئیان (نام علمی: Pseudomonas syringae) نام یک گونه از سرده سودومونا است.
| لکه زاویهای برگکدوئیان | |
|---|---|
![]() | |
| لکه زاویهای برگکدوئیان، Pseudomonas syringae | |
| آرایهشناسی | |
| فرمانرو: | باکتری |
| شاخه: | پروتئوباکتریا |
| رده: | گاماپروتئوباکتریا |
| سرده: | سودومونا |
| گونه: | P. syringae |
| نام علمی | |
| Pseudomonas syringae | |
منابع
- مشارکتکنندگان ویکیپدیا. «Pseudomonas syringae». در دانشنامهٔ ویکیپدیای انگلیسی، بازبینیشده در ۶ مه ۲۰۱۷.
This article is issued from Wikipedia. The text is licensed under Creative Commons - Attribution - Sharealike. Additional terms may apply for the media files.